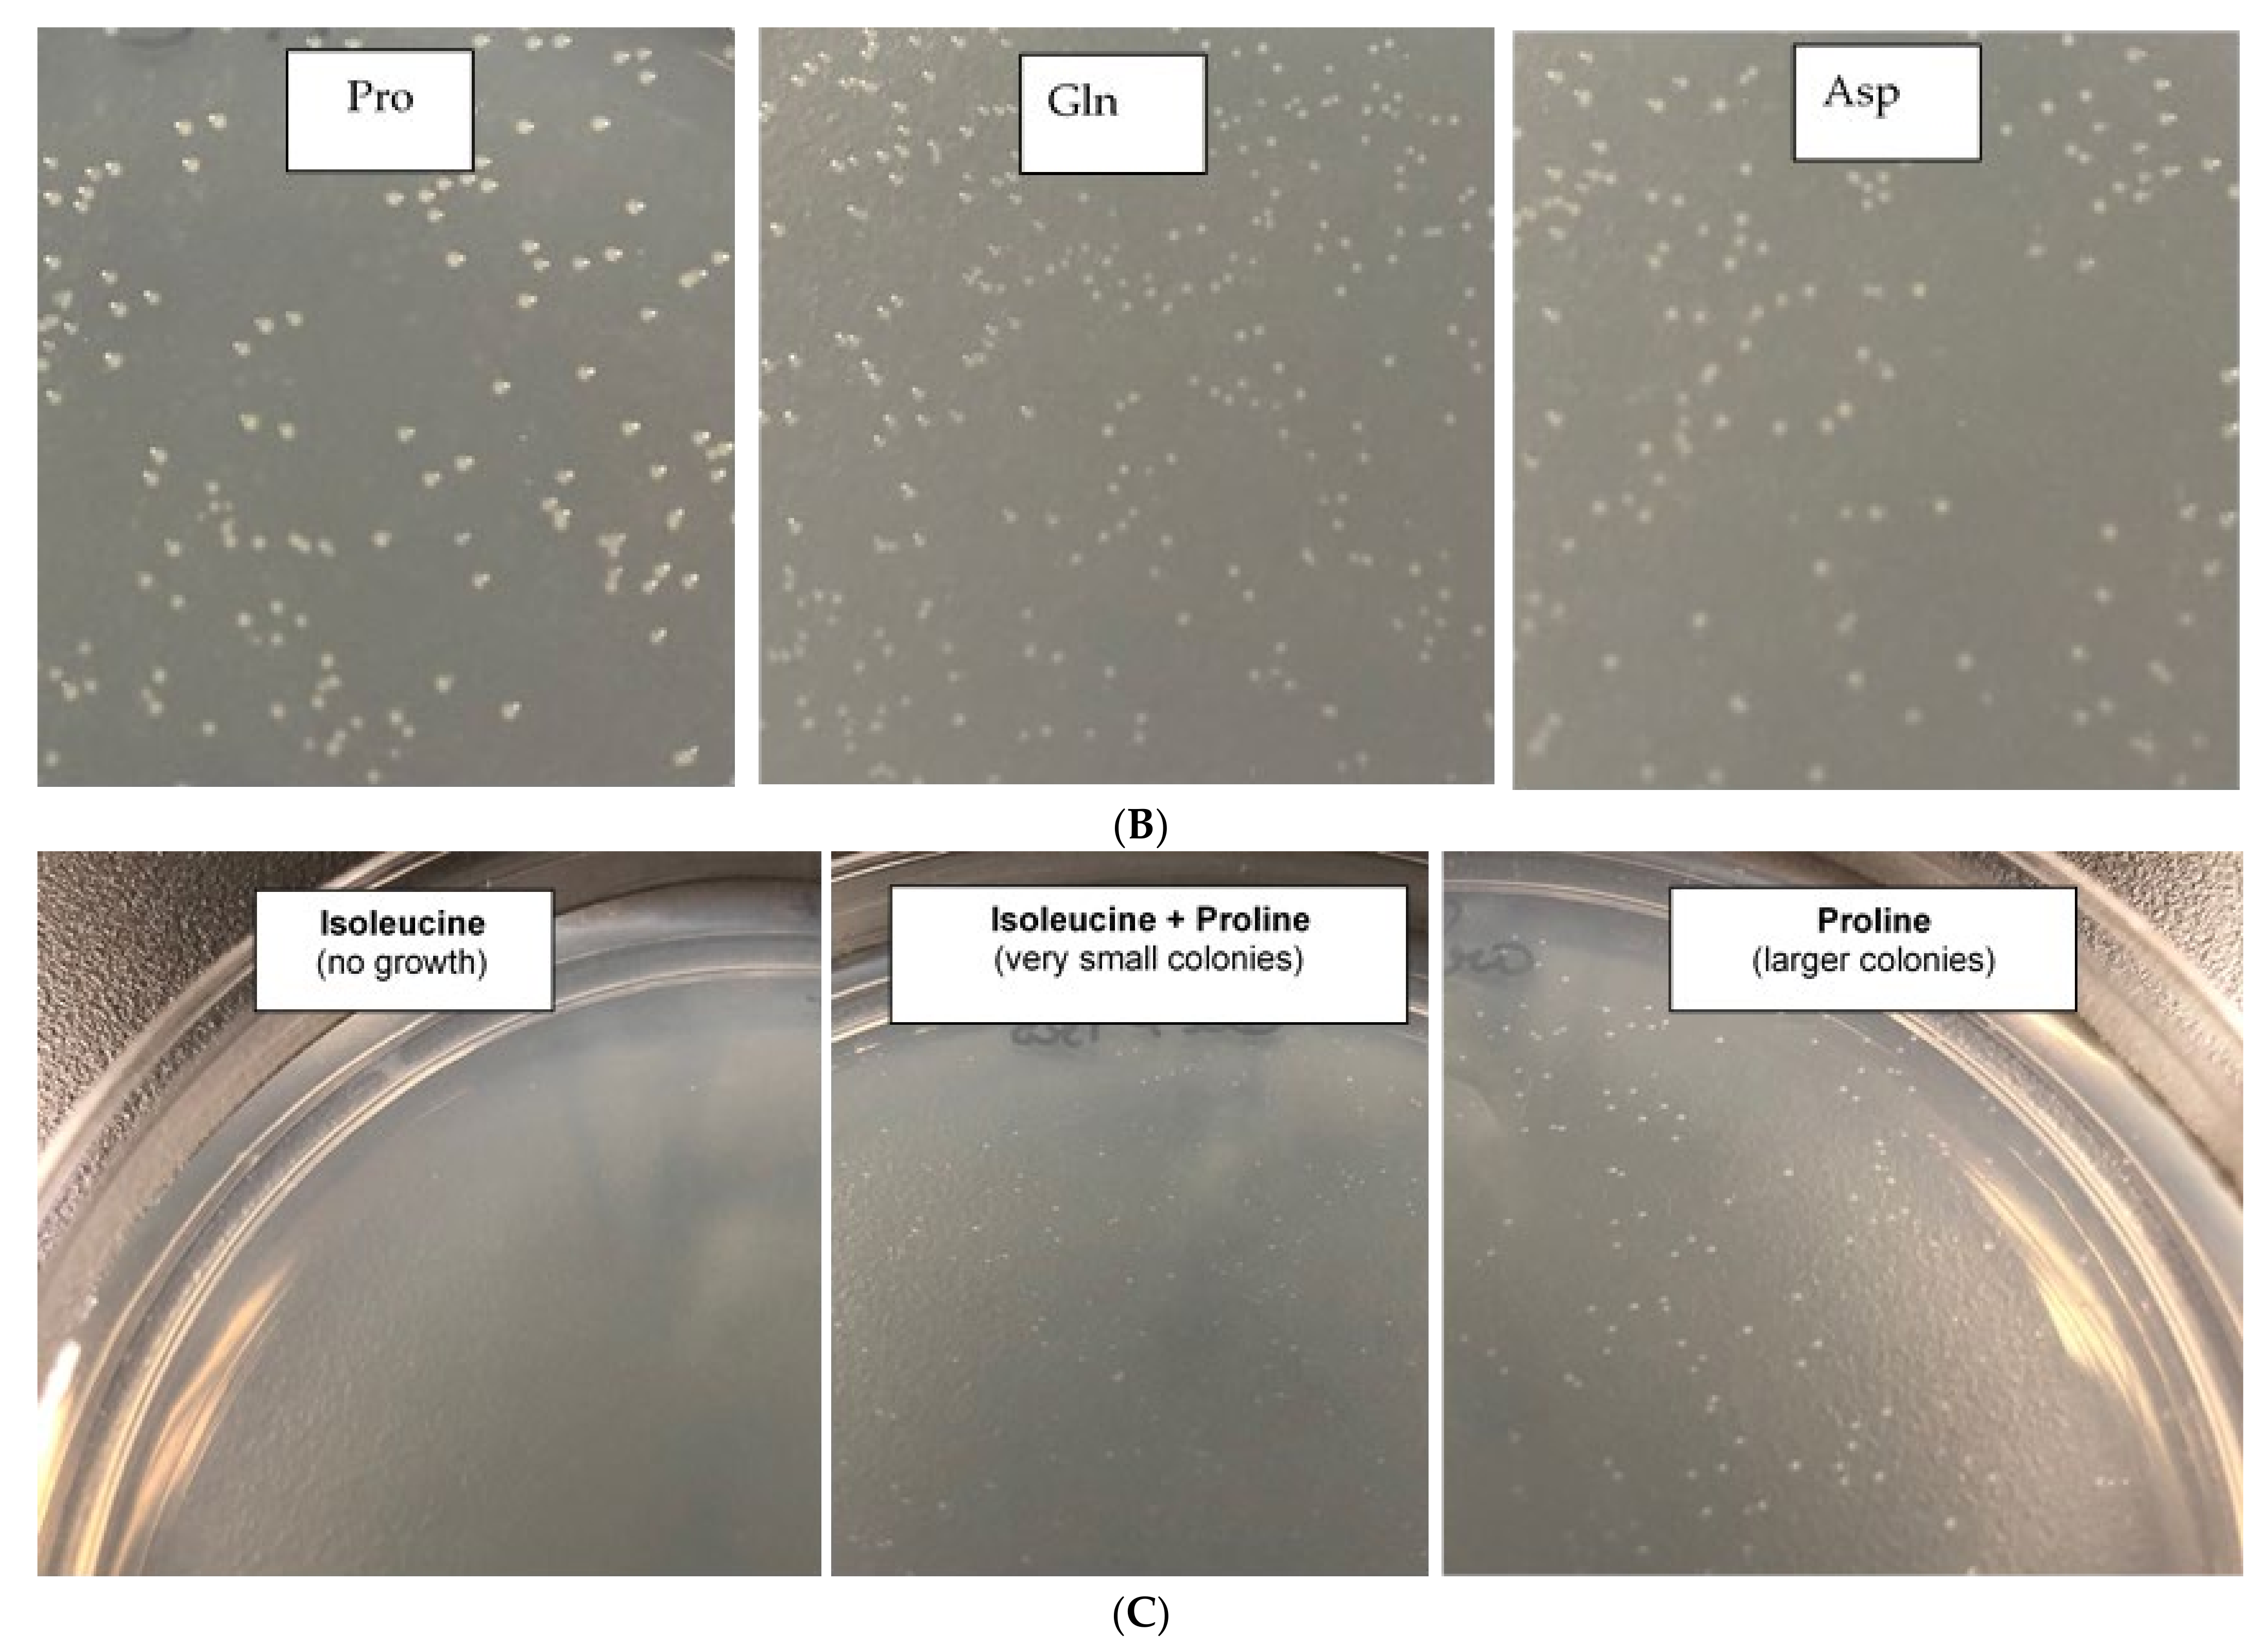
Microorganisms 09 00384 g005b Microorganisms 09 00384 g005b

Persister Cells Form in the Plant Pathogen Xanthomonas citri subsp. citri under Different Stress Conditions
Abstract
1. Introduction
2. Materials and Methods
2.1. Bacterial Strains and Growth Conditions
2.2. Persistence Induced by Chemicals and Persister Cells Killing
2.3. Persistence Induced by Temperature
2.4. Persister Resuscitation by Amino Acids
2.5. Antioxidant Effect of N-Acetylcysteine (NAC) on Metal-Induced Persisters
2.6. Statistical Analysis and Data Presentation
3. Results
3.1. X. citri Triggers Persister Cell Formation under Antibiotic Stress
3.2. Field Stressors Such as Copper, Zinc and High-Temperature also Induce Persisters Cells in X. citri
3.3. X. citri Persister Cells Are Killed by Cisplatin, Mitomycin C, and High Copper Concentrations
3.4. Cu and Zn Ions Induce Persistence by Oxidative Stress
3.5. Specific Amino Acids Affect X. citri Persister Cell Resuscitation
4. Discussion
Author Contributions
Funding
Institutional Review Board Statement
Informed Consent Statement
Data Availability Statement
Acknowledgments
Conflicts of Interest
References
- Gottwald, T.R.; Graham, J.H.; Schubert, T.S. Citrus Canker: The Pathogen and Its Impact. Plant Health Prog. 2002, 3, 15. [Google Scholar] [CrossRef]
- Behlau, F.; Fonseca, A.E.; Belasque, J. A comprehensive analysis of the Asiatic citrus canker eradication programme in São Paulo state, Brazil, from 1999 to 2009. Plant Pathol. 2016, 65, 1390–1399. [Google Scholar] [CrossRef]
- Graham, J.H.; Gottwald, T.R.; Cubero, J.; Achor, D.S. Xanthomonas axonopodis pv. citri: Factors affecting successful eradication of citrus canker. Mol. Plant Pathol. 2004, 5, 1–15. [Google Scholar] [CrossRef] [PubMed]
- Gochez, A.M.; Behlau, F.; Singh, R.; Ong, K.; Whilby, L.; Jones, J.B. Panorama of citrus canker in the United States. Trop. Plant Pathol. 2020, 45, 192–199. [Google Scholar] [CrossRef]
- Behlau, F. An overview of citrus canker in Brazil. Trop. Plant Pathol. 2020, 2020, 1–12. [Google Scholar] [CrossRef]
- Gottwald, T.R.; Irey, M. Post-hurricane Analysis of Citrus Canker II: Predictive Model Estimation of Disease Spread and Area Potentially Impacted by Various Eradication Protocols Following Catastrophic Weather Events. Plant Health Prog. 2007, 8, 22. [Google Scholar] [CrossRef]
- Gottwald, T.R.; Timmer, L. The efficacy of windbreaks in reducing the spread of citrus canker caused by Xanthomonas campestris pv. citri. Trop. Agric. 1995, 72, 194–201. [Google Scholar]
- Behlau, F.; Belasque, J.; Graham, J.H.; Leite, R.P. Effect of frequency of copper applications on control of citrus canker and the yield of young bearing sweet orange trees. Crop Prot. 2010, 29, 300–305. [Google Scholar] [CrossRef]
- Garavaglia, B.S.; Thomas, L.; Zimaro, T.; Gottig, N.; Daurelio, L.D.; Ndimba, B.; Orellano, E.G.; Ottado, J.; Gehring, C. A plant natriuretic peptide-like molecule of the pathogen Xanthomonas axonopodis pv. citri causes rapid changes in the proteome of its citrus host. BMC Plant Biol. 2010, 10, 51. [Google Scholar] [CrossRef]
- De Carvalho, S.A.; de Carvalho-Nunes, W.M.; Belasque, J.; Machado, M.A.; Croce-Filho, J.; Bock, C.H.; Abdo, Z. Comparison of Resistance to Asiatic Citrus Canker Among Different Genotypes of Citrus in a Long-Term Canker-Resistance Field Screening Experiment in Brazil. Plant Dis. 2015, 99, 207–218. [Google Scholar] [CrossRef]
- Hobby, G.L.; Meyer, K.; Chaffee, E. Observations on the Mechanism of Action of Penicillin. Exp. Biol. Med. 1942, 50, 281–285. [Google Scholar] [CrossRef]
- Bigger, J.W. Treatment of staphylococcal infections with penicillin by intermittent sterilisation. Lancet 1944, 244, 497–500. [Google Scholar] [CrossRef]
- Xu, H.-S.; Roberts, N.; Singleton, F.L.; Attwell, R.W.; Grimes, D.J.; Colwell, R.R. Survival and viability of nonculturable Escherichia coli andVibrio cholerae in the estuarine and marine environment. Microb. Ecol. 1982, 8, 313–323. [Google Scholar] [CrossRef]
- Kim, J.-S.; Chowdhury, N.; Yamasaki, R.; Wood, T.K. Viable but non-culturable and persistence describe the same bacterial stress state. Environ. Microbiol. 2018, 20, 2038–2048. [Google Scholar] [CrossRef]
- Song, S.; Wood, T.K. ppGpp ribosome dimerization model for bacterial persister formation and resuscitation. Biochem. Biophys. Res. Commun. 2020, 523, 281–286. [Google Scholar] [CrossRef]
- Kim, J.S.; Yamasaki, R.; Song, S.; Zhang, W.; Wood, T.K. Single cell observations show persister cells wake based on ribosome content. Environ. Microbiol. 2018, 20, 2085–2098. [Google Scholar] [CrossRef]
- Zhang, W.; Yamasaki, R.; Song, S.; Wood, T.K. Interkingdom signal indole inhibits Pseudomonas aeruginosa persister cell waking. J. Appl. Microbiol. 2019, 127, 1768–1775. [Google Scholar] [CrossRef]
- Yamasaki, R.; Song, S.; Benedik, M.J.; Wood, T.K. Persister Cells Resuscitate Using Membrane Sensors that Activate Chemotaxis, Lower cAMP Levels, and Revive Ribosomes. iScience 2020, 23, 100792. [Google Scholar] [CrossRef]
- Lewis, K. Persister Cells. Annu. Rev. Microbiol. 2010, 64, 357–372. [Google Scholar] [CrossRef]
- Megaw, J.; Gilmore, B.F. Archaeal persisters: Persister cell formation as a stress response in Haloferax volcanii. Front. Microbiol. 2017, 8, 1589. [Google Scholar] [CrossRef]
- Ordax, M.; Marco-Noales, E.; López, M.M.; Biosca, E.G. Survival strategy of Erwinia amylovora against copper: Induction of the viable-but-nonculturable state. Appl. Environ. Microbiol. 2006, 72, 3482–3488. [Google Scholar] [CrossRef]
- Santander, R.D.; Català-Senent, J.F.; Marco-Noales, E.; Biosca, E.G. In planta recovery of Erwinia amylovora viable but nonculturable cells. Trees 2012, 26, 75–82. [Google Scholar] [CrossRef]
- Ordax, M.; Biosca, E.G.; Wimalajeewa, S.C.; López, M.M.; Marco-Noales, E. Survival of Erwinia amylovora in mature apple fruit calyces through the viable but nonculturable (VBNC) state. J. Appl. Microbiol. 2009, 107, 106–116. [Google Scholar] [CrossRef]
- Rodrigues, C.M.; Takita, M.A.; Coletta-Filho, H.D.; Olivato, J.C.; Caserta, R.; Machado, M.A.; de Souza, A.A. Copper resistance of biofilm cells of the plant pathogen Xylella fastidiosa. Appl. Microbiol. Biotechnol. 2008, 77, 1145–1157. [Google Scholar] [CrossRef] [PubMed]
- Muranaka, L.S.; Takita, M.A.; Olivato, J.C.; Kishi, L.T.; de Souza, A.A.; Muranaka, L.S.; Takita, M.A.; Olivato, J.C.; Kishi, L.T.; Souza, A.A. De Global Expression Profile of Biofilm Resistance to Antimicrobial Compounds in the Plant-Pathogenic Bacterium Xylella fastidiosa Reveals Evidence of Persister Cells. J. Bacteriol. 2012, 194, 4561. [Google Scholar] [CrossRef] [PubMed]
- Ghezzi, S. Induction of the viable but non-culturable condition in Xanthomonas campestris pv. campestris in liquid microcosms and sterile soil. FEMS Microbiol. Ecol. 1999, 30, 203–208. [Google Scholar] [CrossRef]
- Grey, B.E.; Steck, T.R. The viable but nonculturable state of Ralstonia solanacearum may be involved in long-term survival and plant infection. Appl. Environ. Microbiol. 2001, 67, 3866–3872. [Google Scholar] [CrossRef]
- Van Elsas, J.D.; Kastelein, P.; de Vries, P.M.; van Overbeek, L.S. Effects of ecological factors on the survival and physiology of Ralstonia solanacearum bv. 2 in irrigation water. Can. J. Microbiol. 2001, 47, 842–854. [Google Scholar] [CrossRef]
- Álvarez, B.; López, M.M.; Biosca, E.G. Extended nutrient limitation influences Ralstonia solanacearum survival in natural water microcosms. In Proceedings of the Current Research Topics in Applied Microbiology and Microbial Biotechnology, Seville, Spain, 28 November–1 December 2007; pp. 38–41. [Google Scholar]
- Santander, R.D.; Figàs-Segura, À.; Biosca, E.G. Erwinia amylovora catalases KatA and KatG are virulence factors and delay the starvation-induced viable but non-culturable (VBNC) response. Mol. Plant Pathol. 2017, 19, 922–934. [Google Scholar] [CrossRef] [PubMed]
- Kong, H.G.; Bae, J.Y.; Lee, H.J.; Joo, H.J.; Jung, E.J.; Chung, E.; Lee, S.-W. Induction of the Viable but Nonculturable State of Ralstonia solanacearum by Low Temperature in the Soil Microcosm and Its Resuscitation by Catalase. PLoS ONE 2014, 9, e109792. [Google Scholar] [CrossRef]
- Pandey, N.; Pathak, G.C.; Pandey, D.K.; Pandey, R. Heavy metals, Co, Ni, Cu, Zn and Cd, produce oxidative damage and evoke differential antioxidant responses in spinach. Braz. J. Plant Physiol. 2009, 21, 103–111. [Google Scholar] [CrossRef]
- Thounaojam, T.C.; Panda, P.; Mazumdar, P.; Kumar, D.; Sharma, G.D.; Sahoo, L.; Panda, S.K. Excess copper induced oxidative stress and response of antioxidants in rice. Plant Physiol. Biochem. 2012, 53, 33–39. [Google Scholar] [CrossRef]
- Hamed, S.M.; Zinta, G.; Klöck, G.; Asard, H.; Selim, S.; AbdElgawad, H. Zinc-induced differential oxidative stress and antioxidant responses in Chlorella sorokiniana and Scenedesmus acuminatus. Ecotoxicol. Environ. Saf. 2017, 140, 256–263. [Google Scholar] [CrossRef]
- Gardner, S.P.; Olson, J.W. Interaction of copper toxicity and oxidative stress in Campylobacter jejuni. J. Bacteriol. 2018, 200. [Google Scholar] [CrossRef]
- Singh, R.; Cheng, S.; Singh, S. Oxidative stress-mediated genotoxic effect of zinc oxide nanoparticles on Deinococcus radiodurans. 3 Biotech 2020, 10, 66. [Google Scholar] [CrossRef]
- Gaetke, L.M.; Chow, C.K. Copper toxicity, oxidative stress, and antioxidant nutrients. Toxicology 2003, 189, 147–163. [Google Scholar] [CrossRef]
- Grass, G.; Rensing, C.; Solioz, M. Metallic copper as an antimicrobial surface. Appl. Environ. Microbiol. 2011, 77, 1541–1547. [Google Scholar] [CrossRef]
- Chandrangsu, P.; Rensing, C.; Helmann, J.D. Metal homeostasis and resistance in bacteria. Nat. Rev. Microbiol. 2017, 15, 338–350. [Google Scholar] [CrossRef]
- Martins, P.M.M.; Merfa, M.V.; Takita, M.A.; de Souza, A.A. Persistence in phytopathogenic bacteria: Do we know enough? Front. Microbiol. 2018, 9, 1099. [Google Scholar] [CrossRef]
- Da Silva, A.C.R.; Ferro, J.A.; Reinach, F.C.; Farah, C.S.; Furlan, L.R.; Quaggio, R.B. Comparison of the genomes of two Xanthomonas pathogens with differing host specificities. Nature 2002, 417–463. [Google Scholar] [CrossRef]
- Rodriguez, R.L.; Tait, R.C. Recombinant DNA Techniques: An Introduction; Benjamin/Cummings Publishing: Menlo Park, CA, USA, 1983; p. 236. [Google Scholar]
- Kwan, B.W.; Valenta, J.A.; Benedik, M.J.; Wood, T.K. Arrested protein synthesis increases persister-like cell formation. Antimicrob. Agents Chemother. 2013, 57, 1468–1473. [Google Scholar] [CrossRef]
- Martins, P.M.M.; Gong, T.; de Souza, A.A.; Wood, T.K. Copper Kills Escherichia coli Persister Cells. Antibiotics 2020, 9, 506. [Google Scholar] [CrossRef]
- Graham, J.H.; Johnson, E.G.; Myers, M.E.; Young, M.; Rajasekaran, P.; Das, S.; Santra, S. Potential of nano-formulated zinc oxide for control of citrus canker on grapefruit trees. Plant Dis. 2016, 100, 2442–2447. [Google Scholar] [CrossRef]
- Sumares, J.A.P.; Morão, L.G.; Martins, P.M.M.; Martins, D.A.B.; Gomes, E.; Belasque, J.; Ferreira, H. Temperature stress promotes cell division arrest in Xanthomonas citri subsp. citri. Microbiologyopen 2016, 5, 244–253. [Google Scholar] [CrossRef]
- Cabot, C.; Martos, S.; Llugany, M.; Gallego, B.; Tolrà, R.; Poschenrieder, C. A Role for Zinc in Plant Defense Against Pathogens and Herbivores. Front. Plant Sci. 2019, 10, 1171. [Google Scholar] [CrossRef]
- Chowdhury, N.; Wood, T.L.; Martínez-Vázquez, M.; García-Contreras, R.; Wood, T.K. DNA-crosslinker cisplatin eradicates bacterial persister cells. Biotechnol. Bioeng. 2016, 113, 1984–1992. [Google Scholar] [CrossRef]
- Kwan, B.W.; Chowdhury, N.; Wood, T.K. Combatting bacterial infections by killing persister cells with mitomycin C. Environ. Microbiol. 2015, 17, 4406–4414. [Google Scholar] [CrossRef]
- Cruz-Muñiz, M.Y.; López-Jacome, L.E.; Hernández-Durán, M.; Franco-Cendejas, R.; Licona-Limón, P.; Ramos-Balderas, J.L.; Martinéz-Vázquez, M.; Belmont-Díaz, J.A.; Wood, T.K.; García-Contreras, R. Repurposing the anticancer drug mitomycin C for the treatment of persistent Acinetobacter baumannii infections. Int. J. Antimicrob. Agents 2017, 49, 88–92. [Google Scholar] [CrossRef]
- Vincent, M.; Duval, R.E.; Hartemann, P.; Engels-Deutsch, M. Contact killing and antimicrobial properties of copper. J. Appl. Microbiol. 2018, 124, 1032–1046. [Google Scholar] [CrossRef]
- Hong, S.H.; Wang, X.; O’Connor, H.F.; Benedik, M.J.; Wood, T.K. Bacterial persistence increases as environmental fitness decreases. Microb. Biotechnol. 2012, 5, 509–522. [Google Scholar] [CrossRef]
- Aldini, G.; Altomare, A.; Baron, G.; Vistoli, G.; Carini, M.; Borsani, L.; Sergio, F. N-Acetylcysteine as an antioxidant and disulphide breaking agent: The reasons why. Free Radic. Res. 2018, 52, 751–762. [Google Scholar] [CrossRef]
- Qiao, K.; Liu, Q.; Xia, Y.; Zhang, S. Evaluation of a Small-Molecule Compound, N-Acetylcysteine, for the Management of Bacterial Spot of Tomato Caused by Copper-Resistant Xanthomonas perforans. Plant Dis. 2021, 105, 108–113. [Google Scholar] [CrossRef]
- Picchi, S.C.; Takita, M.A.; Coletta-Filho, H.D.; Machado, M.A.; de Souza, A.A. N-acetylcysteine interferes with the biofilm formation, motility and epiphytic behaviour of Xanthomonas citri subsp. citri. Plant Pathol. 2016, 65, 561–569. [Google Scholar] [CrossRef]
- Lamichhane, J.R.; Osdaghi, E.; Behlau, F.; Köhl, J.; Jones, J.B.; Aubertot, J.N. Thirteen decades of antimicrobial copper compounds applied in agriculture. A review. Agron. Sustain. Dev. 2018, 38, 1–18. [Google Scholar] [CrossRef]
- Behlau, F.; Belasque, J., Jr. Cancro Cítrico: A Doença e Seu Controle; Fundecitrus: Araraquara, Brazil, 2014; ISBN 978-85-68170-00-7. [Google Scholar]
- Hippler, F.W.R.; Petená, G.; Boaretto, R.M.; Quaggio, J.A.; Azevedo, R.A.; Mattos, D., Jr. Mechanisms of copper stress alleviation in Citrus trees after metal uptake by leaves or roots. Environ. Sci. Pollut. Res. 2018, 25, 13134–13146. [Google Scholar] [CrossRef]
- Alva, A.K.; Graham, J.H.; Anderson, C.A. Soil pH and Copper Effects on Young ‘Hamlin’ Orange Trees. Soil Sci. Soc. Am. J. 1995, 59, 481–487. [Google Scholar] [CrossRef]
- Holm, T.R. Copper complexation by natural organic matter in contaminated and uncontaminated ground water. Chem. Speciat. Bioavailab. 1990, 2, 63–76. [Google Scholar] [CrossRef]
- Karlsson, H.L.; Cronholm, P.; Hedberg, Y.; Tornberg, M.; de Battice, L.; Svedhem, S.; Wallinder, I.O. Cell membrane damage and protein interaction induced by copper containing nanoparticles-Importance of the metal release process. Toxicology 2013, 313, 59–69. [Google Scholar] [CrossRef]
- Kim, J.S.; Wood, T.K. Persistent persister misperceptions. Front. Microbiol. 2016, 7, 2134. [Google Scholar] [CrossRef]
- Griebel, T.; Zeier, J. Light regulation and daytime dependency of inducible plant defenses in Arabidopsis: Phytochrome signaling controls systemic acquired resistance rather than local defense. Plant Physiol. 2008, 147, 790–801. [Google Scholar] [CrossRef]
- Santander, R.D.; Monte-Serrano, M.; Rodríguez-Herva, J.J.; López-Solanilla, E.; Rodríguez-Palenzuela, P.; Biosca, E.G. Exploring new roles for the rpoS gene in the survival and virulence of the fire blight pathogen Erwinia amylovora. FEMS Microbiol. Ecol. 2014, 90, 895–907. [Google Scholar] [CrossRef] [PubMed]
- Vilchèze, C.; Hartman, T.; Weinrick, B.; Jain, P.; Weisbrod, T.R.; Leung, L.W.; Freundlich, J.S.; Jacobs, W.R. Enhanced respiration prevents drug tolerance and drug resistance in Mycobacterium tuberculosis. Proc. Natl. Acad. Sci. USA 2017, 114, 4495–4500. [Google Scholar] [CrossRef]
- Defraine, V.; Fauvart, M.; Michiels, J. Fighting bacterial persistence: Current and emerging anti-persister strategies and therapeutics. Drug Resist. Updat. 2018, 38, 12–26. [Google Scholar] [CrossRef] [PubMed]
- Yang, C.R.; Shapiro, B.E.; Hung, S.P.; Mjolsness, E.D.; Hatfield, G.W. A mathematical model for the branched chain amino acid biosynthetic pathways of Escherichia coli K12. J. Biol. Chem. 2005, 25, 11224–11232. [Google Scholar] [CrossRef] [PubMed]
- Varik, V.; Oliveira, S.R.A.; Hauryliuk, V.; Tenson, T. Composition of the outgrowth medium modulates wake-up kinetics and ampicillin sensitivity of stringent and relaxed Escherichia coli. Sci. Rep. 2016, 6, 22308. [Google Scholar] [CrossRef] [PubMed]

Publisher’s Note: MDPI stays neutral with regard to jurisdictional claims in published maps and institutional affiliations. |
© 2021 by the authors. Licensee MDPI, Basel, Switzerland. This article is an open access article distributed under the terms and conditions of the Creative Commons Attribution (CC BY) license (http://creativecommons.org/licenses/by/4.0/).
Share and Cite
Martins, P.M.M.; Wood, T.K.; de Souza, A.A. Persister Cells Form in the Plant Pathogen Xanthomonas citri subsp. citri under Different Stress Conditions. Microorganisms 2021, 9, 384. https://doi.org/10.3390/microorganisms9020384
Martins PMM, Wood TK, de Souza AA. Persister Cells Form in the Plant Pathogen Xanthomonas citri subsp. citri under Different Stress Conditions. Microorganisms. 2021; 9(2):384. https://doi.org/10.3390/microorganisms9020384
Chicago/Turabian StyleMartins, Paula M. M., Thomas K. Wood, and Alessandra A. de Souza. 2021. "Persister Cells Form in the Plant Pathogen Xanthomonas citri subsp. citri under Different Stress Conditions" Microorganisms 9, no. 2: 384. https://doi.org/10.3390/microorganisms9020384
APA StyleMartins, P. M. M., Wood, T. K., & de Souza, A. A. (2021). Persister Cells Form in the Plant Pathogen Xanthomonas citri subsp. citri under Different Stress Conditions. Microorganisms, 9(2), 384. https://doi.org/10.3390/microorganisms9020384

